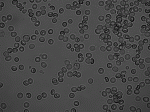
�tѪ��

信息分類:站內(nèi)新聞
作者:yiyi發(fā)布
時間:2012-1-25 17:53:54
將本頁加入收藏
下一篇:螃蟹卵一孵出的樣子要拿顯微鏡才能看出!
上一篇:蒼蠅顯微鏡下放大25倍暗視野拍攝照片!
點(diǎn)擊查看產(chǎn)品參數(shù)和報價--丨--
---
---
---
正文:
相位差(相襯顯微鏡)紅細(xì)胞顯微鏡照片!
口腔表皮細(xì)胞
位相差拍攝,放大400倍。 
口腔表皮細(xì)胞
位相差拍攝,放大400倍。 
紅血球
明視野拍攝,放大400倍。
紅血球
明視野拍攝,放大400倍。
紅血球
位相差拍攝,放大400倍。
合作伙伴: